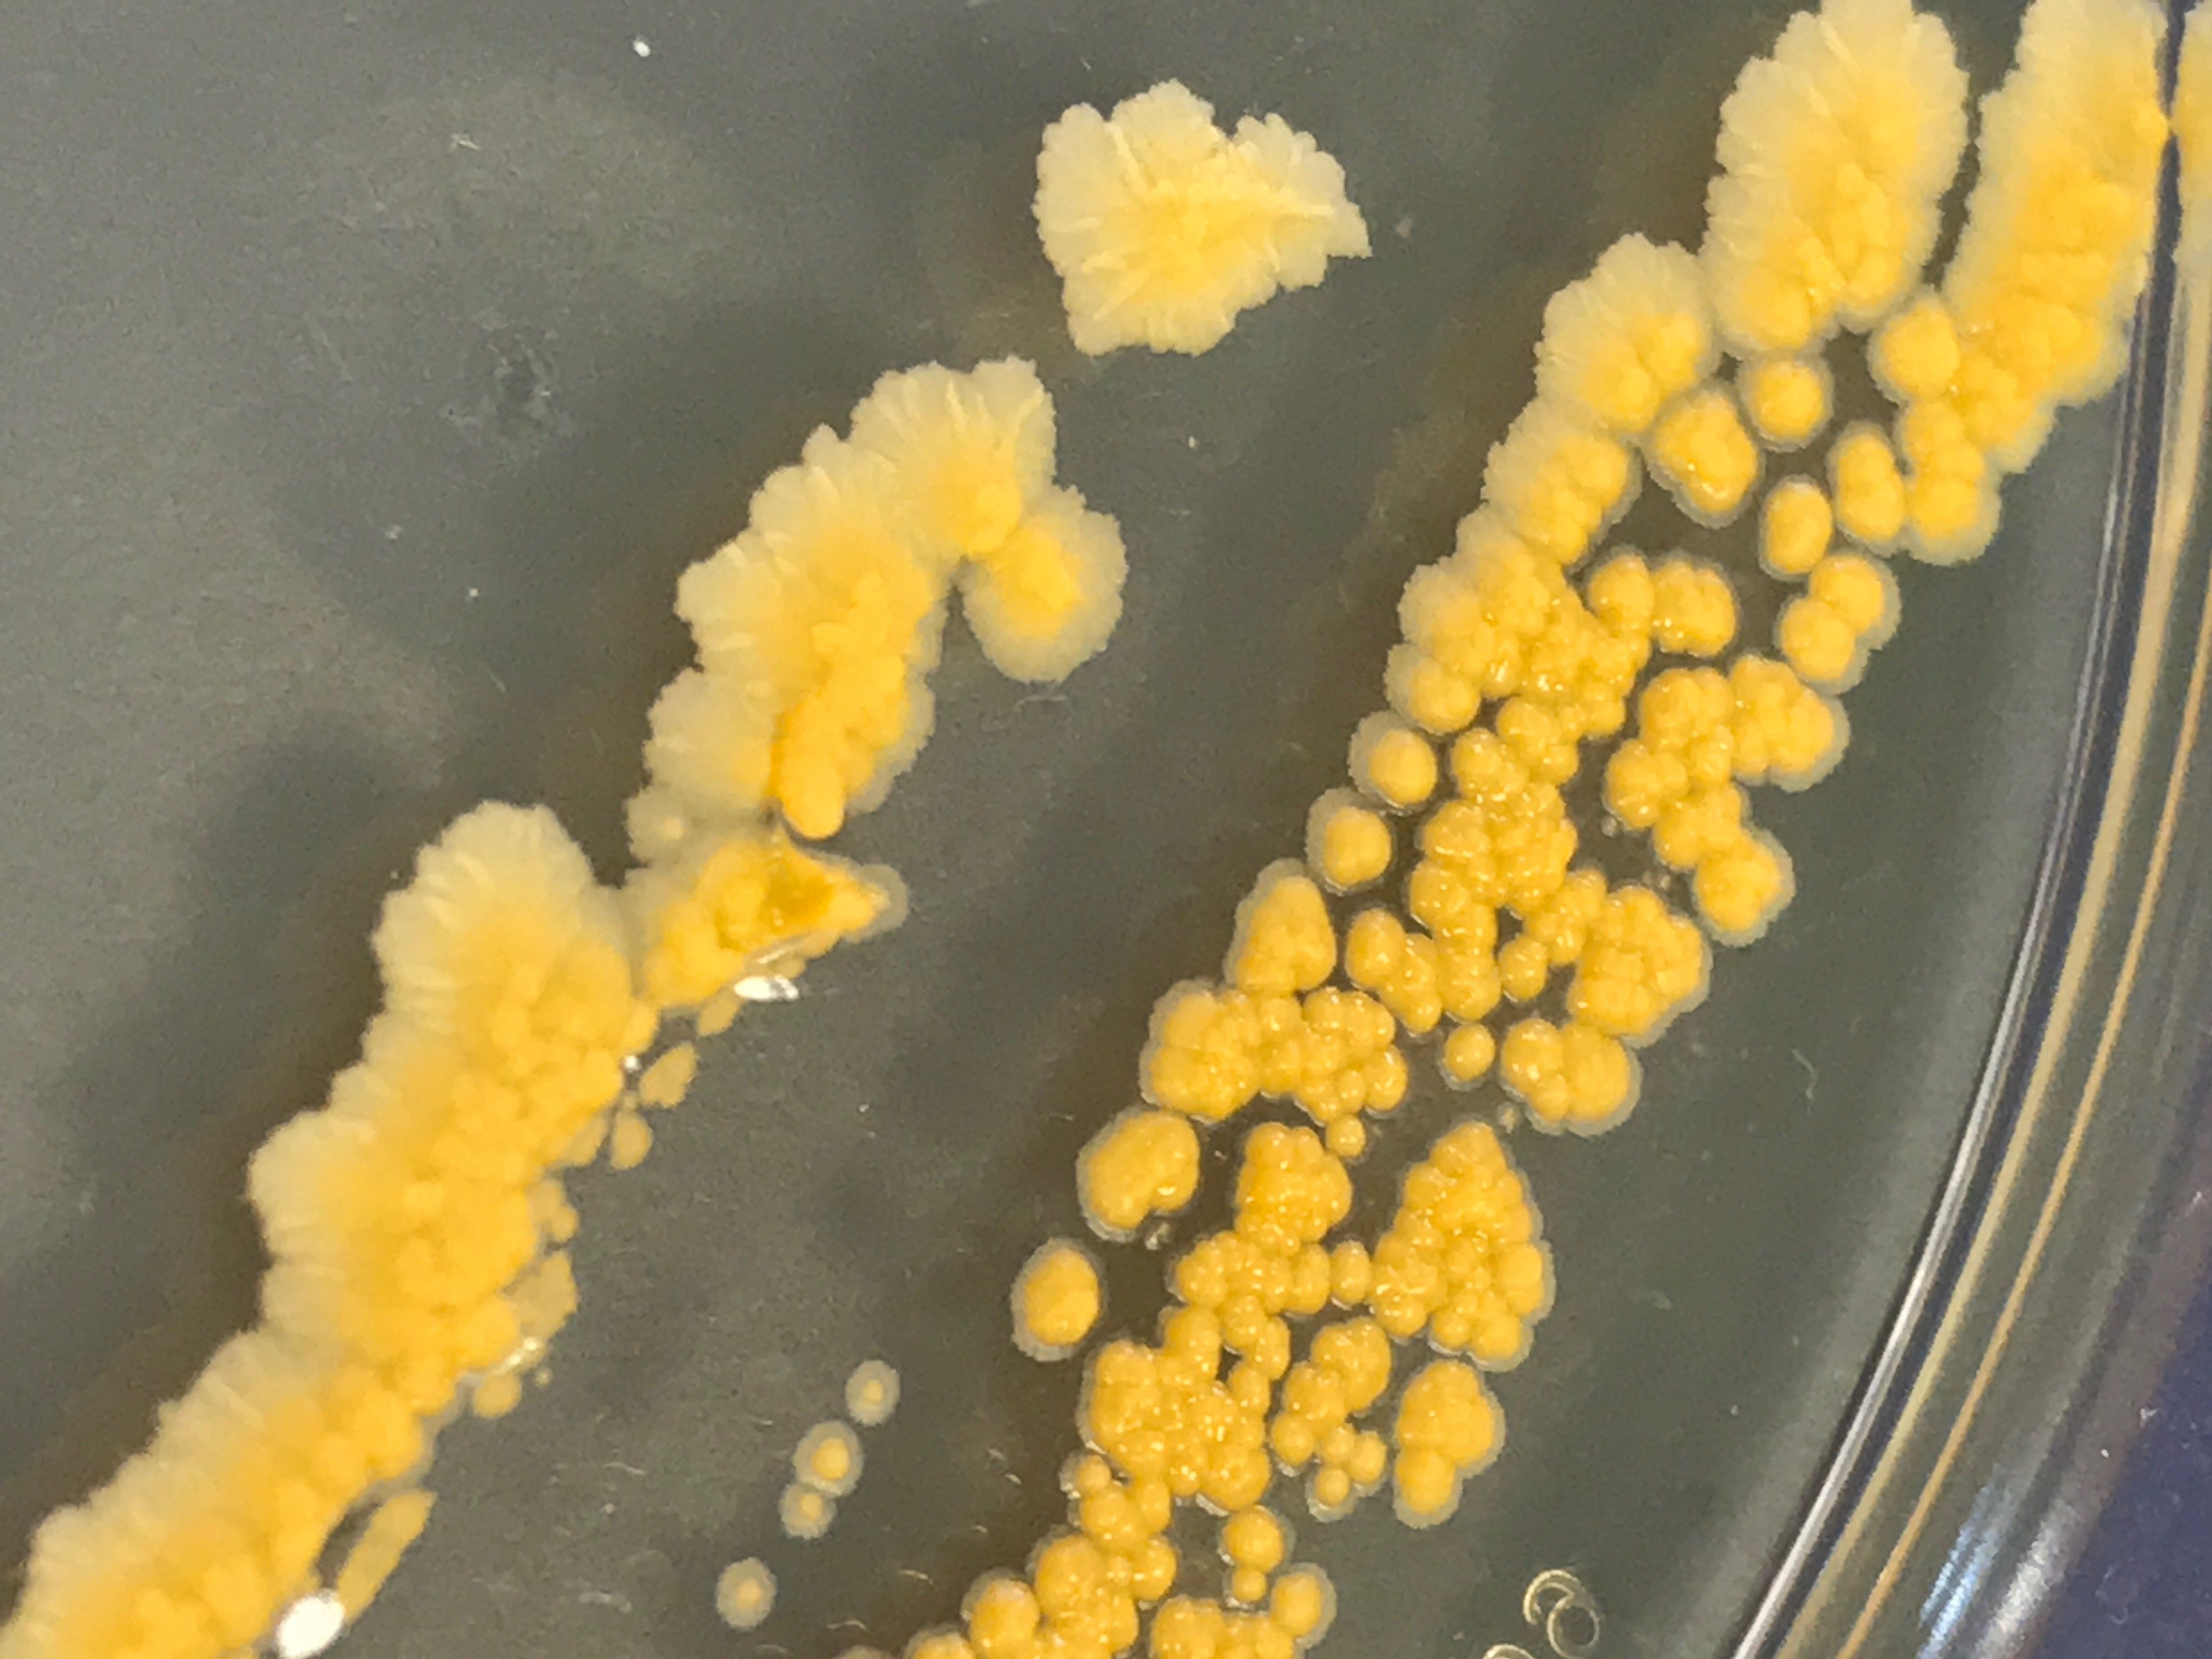

The survival mechanisms of polar fish have led scientists at the University of Warwick to develop of a revolutionary approach to ‘freeze’ bacteria.
The new technique could radically improve the work to store and transport human tissue.
Researchers from the Department of Chemistry and Warwick Medical School have established a way to cryopreserve (or ‘freeze’) a broad range of bacteria using synthetic reproductions of the natural antifreeze proteins found in polar organisms.
They found that adding the protein mimics slows ice crystal growth and stops them destroying the bacteria cells.
The revolutionary method has potential applications within the food industry, organ transportation and medicine - as well as in laboratory research.
Bacteria are used in a vast range of processes including food technology (e.g. In yoghurt and probiotics), pharmaceutical manufacturing (e.g. insulin) and enzyme production (e.g. for washing powders) and they are routinely used in research labs to study infection and the fundamentals of living processes.
Read more at University of Warwick
Image: Bacteria growing after being frozen. CREDIT: University of Warwick